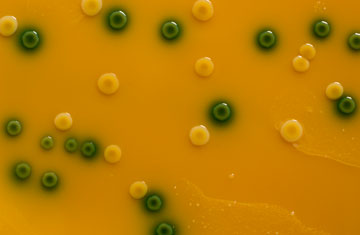
villorejo/iStockphoto/Thinkstock

Listeria developing resistance to disinfectants, researchers find
One of the most common causes of foodborne diseases, listeria, is developing resistance to some of the most frequently used disinfectants that dairy processors use to get rid of the bacterium, a new study published in the journal Plos One has revealed.
For many years, dairy producers have been relying on preventing contamination by killing the bacterium Listeria monocytogenes, which typically causes listeriosis. The bacterium is most common in dairy products but can also be found on leafy vegetables. In order to kill the bacteria, various disinfectants are used but most often manufacturers apply quaternary ammonium compounds such as benzalkonium chloride.
RELATED: Foodborne illnesses linked to leafy vegetables, dairy on the rise
However, a team of researchers at the University of Veterinary Medicine in Vienna has discovered that many strains of listeria are developing resistance to such disinfectants. Why and how this happens is still to be examined but researchers have found that a new piece of DNA in the bacteria is related to the change.
The team of academics called this element Tn6188, discovered in the DNA sequence of two types of listeria that are known to be resistant to benzalkonium chloride. Trying to rule out the possibility of a mere coincidence, researchers then looked for the same element in another 90 strains of listeria and discovered it in ten of them. In follow-up research these ten strains also proved less sensitive to the active agent in disinfectants, confirming their discovery.
Researchers recommend that food-processing facilities should be disinfected thoroughly to ensure that any resistant bacteria are eliminated, the university said.